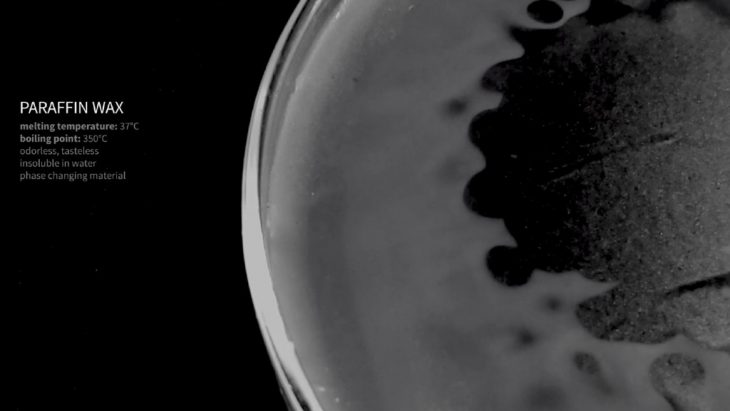

Self sufficient buildings // Wax Lightscape
Envisioning Energy – Paraffin Wax
This project aims to create a space that transforms itself according to the light that reaches its interior. Using a phase changing material (wax) as a medium, the geometry can take different configurations and allow for more focused or more diffused light in specific places.
// VARIABLES
light | temperature | volume | time | diameter | pressure
Water is used as an instrument to quickly cool and solidify the wax, and the outputs of water are controlled by a computational analysis of temperature and light permeability. The spots that initially receive more water, with a higher pressure, will have a higher permeability of light.
The site’s initial conditions were mapped, starting from its limits and evolving to the energies that influence the process. The walls of the surrounding apartment units were drawn as a way to understand the space. The existing pipes were traced in order to comprehend the flow of water in the site, so that they could be connected to the inputs and outputs of water in the system. The sun path was studied in order to maximize the solar radiation that reaches the container, so that there’s enough heat to melt the wax and enough natural light within the landscape.
Through Computational analysis we understand the ratio between top and bottom openings, as well as the depth, result in areas of more intense light. The system receives information about how much water should be dropped in each point of discharge, according to how much light is desired in that spot.
It is a very dynamic system, since the process happens in a cycle and the surface can change completely from one iteration to another and the geometry is governed by temperature, volume, pressure and time, with light as an output.
Wax Lightscape is a project of IaaC, Institute for Advanced Architecture of Catalonia developed at MAA01 in 2019-20 by:
Students: Ahmad AlBaalbaky | Brenda Freitas | Nitha Shivapuram
Faculty: Edouard Cabay | Peter Geelmuyden Magnus | Oana Taut